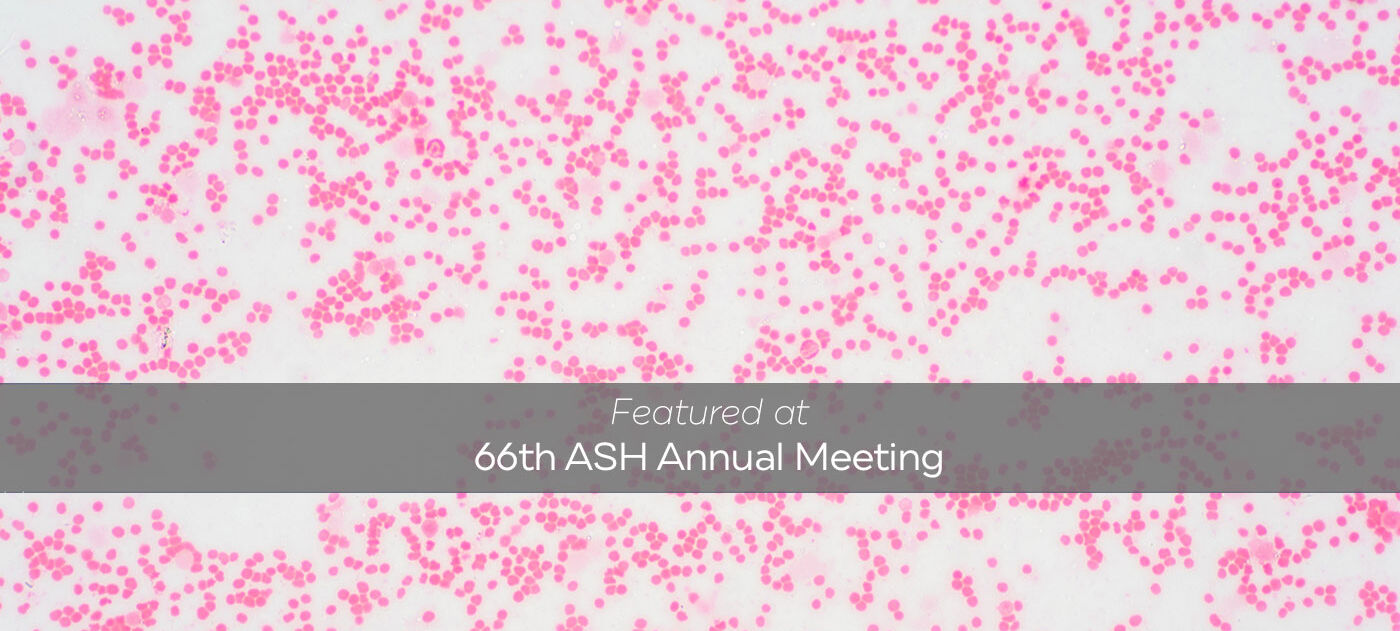

Drug Offers New Option for Patients With Rare Blood Disorders in ‘No Man’s Land’
Myelodysplastic/myeloproliferative neoplasms are a group of diseases that occur when bone marrow produces too many blood cells while also demonstrating evidence of dysfunctional blood cell production, thereby having characteristics of both myelodysplastic syndromes and myeloproliferative neoplasms. Consensus for treating patients with these diseases is lacking, and patients are often excluded from clinical trials.
This puts patients with myelodysplastic/myeloproliferative neoplasms in a “no man’s land,” says Andrew Kuykendall, MD, a hematologist at Moffitt Cancer Center.
Since the syndromes can present with symptoms similar to those seen in myelofibrosis, a rare type of bone marrow cancer, Kuykendall decided to investigate if a myelofibrosis treatment could be effective in myelodysplastic/myeloproliferative neoplasms.
A phase 2 trial presented at the American Society of Hematology annual meeting assessed the efficacy of a JAK inhibitor called fedratinib in patients with myelodysplastic/myeloproliferative neoplasms or chronic neutrophilic leukemia. A JAK inhibitor is a type of medication that treats inflammation driven by malignant or inflammatory disorders by blocking the body’s production of cytokines, or proteins that cause inflammation.

Andrew Kuykendall, MD
“Fedratinib, interestingly, is also caught in ‘no man’s land’ within the treatment paradigm of myelofibrosis despite demonstrating significant potency. It was the second of four approved JAK inhibitors but has failed to establish a clear niche,” Kuykendall said.
Twenty-four patients on the trial received fedratinib daily. After 24 weeks, 53% of patients responded to the treatment. Half of patients had a symptom response, and 37.5% had a spleen response.
“This is a very high-risk group of patients who frequently harbor clinical characteristics that would suggest less likelihood of responding to treatment, so it is encouraging that fedratinib was able to achieve response rates of this magnitude,” Kuykendall said. “This data suggests that this is a very reasonable treatment option for these patients.”
Kuykendall says that while the results are promising, fedratinib does not replace allogeneic stem cell transplants, which should be the goal for eligible patients with these diseases. The drug, however, can be used to bridge patients to transplant.
“I also think one of the biggest takeaways from this study for me is that you can enroll a trial with a very rare disease,” Kuykendall said. “One of the reasons people don’t necessarily put resources behind these rare diseases is because they fear they can’t enroll, and I think we proved that’s not the case.”